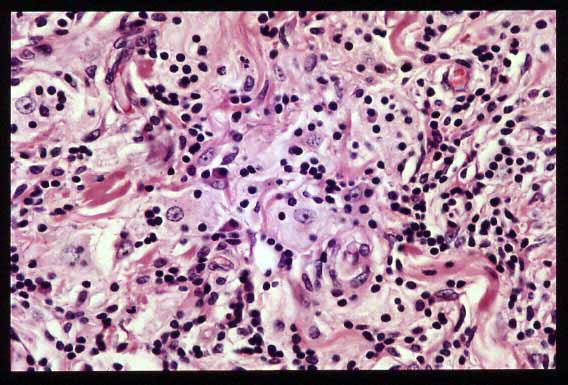
Figura 6

Comunicación
Nş 033
Comunicación |
Agustin Chong Lopez(1), Gershom C Ejeckham(2), Abdulrazzaq Haider(2), Sheikha Al-Thani(2)
 |
| Figura 1. Imagen de la pieza macroscópica. |
 |
| Figura 2. Esta foto panorámica muestra la epidermis y la dermis sin alteraciones. H y E X40. |
 |
| Figura 3. Se destacan las áreas histiocíticas y los tabiques fibrosos. PAS X40 |
 |
| Figura 4. En este menor aumento se observan los folículos linfoides secundarios alrededor de los lóbulos histiocitarios. H y E X40 |
 |
| Figura 5. Observamos una importante infiltración intersticial por linfocitos y plasmocitos. H y E X100. |
|
| Figura 6. Células linfoplasmocitarias dentro del citoplasma de los histiocitos. H y E X200. |